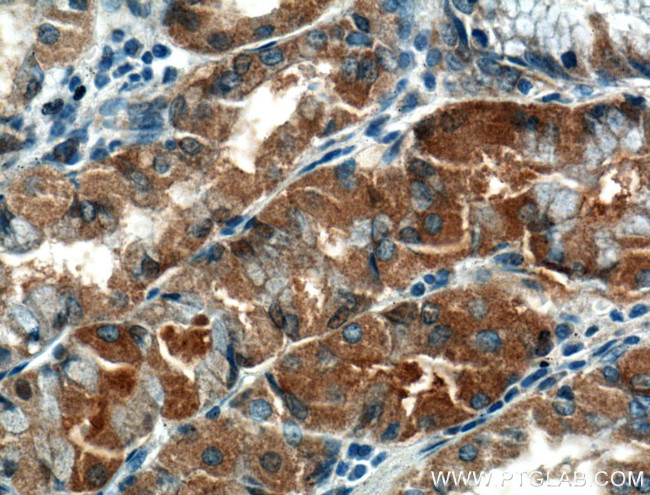
TMEM208 Antibody in Immunohistochemistry (Paraffin) (IHC (P))

Search
Proteintech
TMEM208 Polyclonal Antibody
{{$productOrderCtrl.translations['antibody.pdp.commerceCard.promotion.promotions']}}
{{$productOrderCtrl.translations['antibody.pdp.commerceCard.promotion.viewpromo']}}
{{$productOrderCtrl.translations['antibody.pdp.commerceCard.promotion.promocode']}}: {{promo.promoCode}} {{promo.promoTitle}} {{promo.promoDescription}}. {{$productOrderCtrl.translations['antibody.pdp.commerceCard.promotion.learnmore']}}
产品信息
23882-1-AP
种属反应
宿主/亚型
分类
类型
抗原
偶联物
形式
浓度
规格
纯化类型
保存液
内含物
保存条件
运输条件
产品详细信息
Immunogen sequence: MAPKGKVGT RGKKQIFEEN RETLKFYLRI ILGANAIYCL VTLVFFYSSA SFWAWLALGF SLAVYGASYH SMSSMARAAF SEDGALMDGG MDLNMEQGMA EHLKDVILLT AIVQVLSCFS LYVWSFWLLA PGRALYLLWV NVLGPWFTAD SGTPAPEHNE KRQRRQERRQ MKRL (1-173 aa encoded by BC003080)
靶标信息
May function as a negative regulator of endoplasmic reticulum-stress induced autophagy.
仅用于科研。不用于诊断过程。未经明确授权不得转售。
生物信息学
蛋白别名: SRP-independent targeting 2 homolog; Transmembrane protein 208
基因别名: 1700006C06Rik; 2610030K20Rik; hSND2; HSPC171; SND2; TMEM208
UniProt ID: (Human) Q9BTX3, (Mouse) Q9CR96
Entrez Gene ID: (Human) 29100, (Mouse) 66320